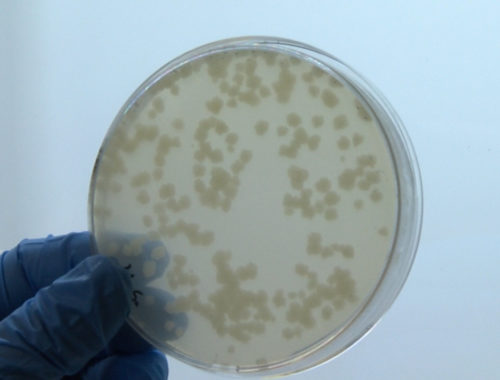

Esta web utiliza cookies para que podamos ofrecerte la mejor experiencia de usuario posible. La información de las cookies se almacena en tu navegador y realiza funciones tales como reconocerte cuando vuelves a nuestra web o ayudar a nuestro equipo a comprender qué secciones de la web encuentras más interesantes y útiles.
Resumen de Privacidad
Cookies estrictamente necesarias
Las cookies estrictamente necesarias tiene que activarse siempre para que podamos guardar tus preferencias de ajustes de cookies.
If you disable this cookie, we will not be able to save your preferences. This means that every time you visit this website you will need to enable or disable cookies again.
Cookies de Terceros
Esta web utiliza Google Analytics para recopilar información anónima tal como el número de visitantes del sitio, o las páginas más populares.
Dejar esta cookie activa nos permite mejorar nuestra web.
Please enable Strictly Necessary Cookies first so that we can save your preferences!